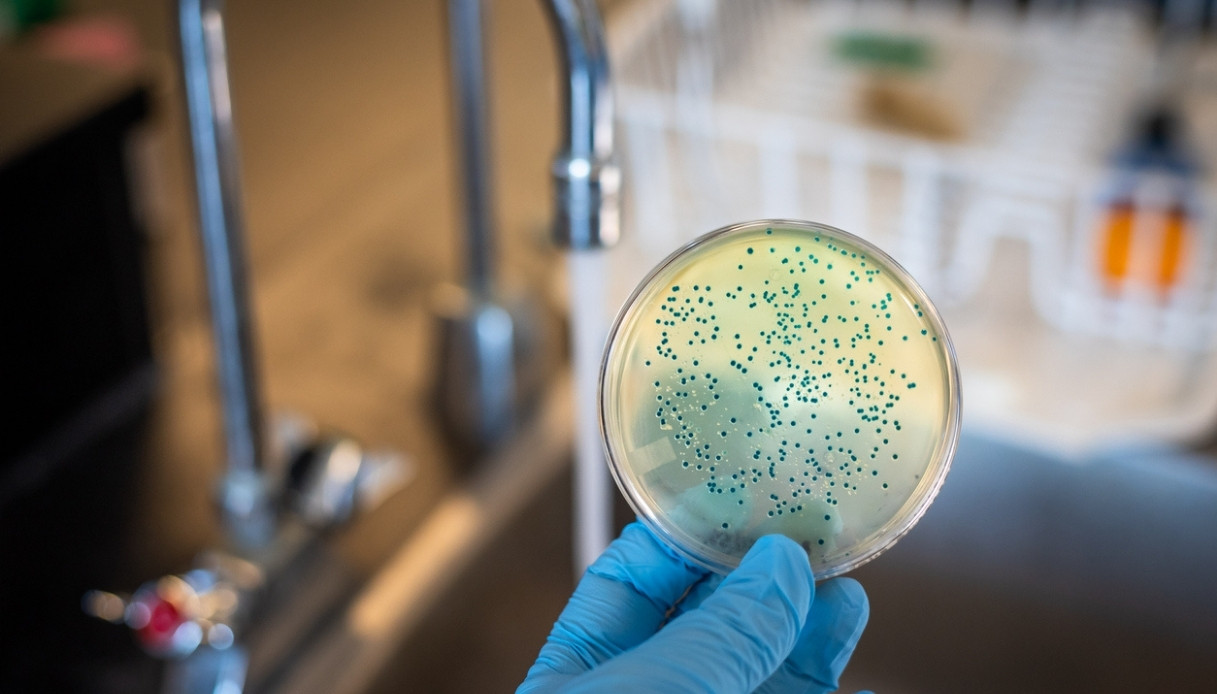

Creati i primi virus con l’AI | un’alternativa possibile agli antibiotici
La scoperta potrebbe rappresentare una rivoluzione e soprattutto una soluzione al problema dell’antibiotico-resistenza in crescita, ossia la sempre maggiore inefficacia degli attuali antibiotici contro molti tipi di batteri. In laboratorio, infatti, sono stati creati i primi virus, ricorrendo all’ intelligenza artificiale (AI). In particolare si tratterebbe di virus “batteriofagi”, ossia in grado di “uccidere” alcuni batteri. Creati i primi virus sintetici. I nuovi virus possono essere considerati del tutto “artificiali”, perché non esistono in natura e sono stati creati grazie al ricorso all’ intelligenza artificiale. 🔗 Leggi su Dilei.it
© Dilei.it - Creati i primi virus con l’AI: un’alternativa possibile agli antibiotici
In questa notizia si parla di: creati - primi
Creati i primi virus con l’intelligenza artificiale (IA): possono uccidere organismi viventi
Il giardino delle mie emozioni Si tratta di un atelier dedicato alla sperimentazione, alla fantasia e alla creatività con un occhio di riguardo alle emozioni dei bambini e delle bambine. Dopo i primi incontri creeremo assieme una bellissima storia illustrata! C - facebook.com Vai su Facebook
Creati i primi virus con l’AI: un’alternativa possibile agli antibiotici - I nuovi virus creati con l’AI sarebbero in grado di distruggere anche alcuni ceppi di Escherichia coli, che colpisce l’intestino con gastroenteriti ... Come scrive dilei.it
Creati i primi virus progettati dall'intelligenza artificiale - Un gruppo di scienziati ha usato l'IA per scrivere interi genomi virali, e li ha poi utilizzati per sintetizzare batteriofagi in grado di uccidere diversi ceppi di batteri resistenti. Scrive lescienze.it